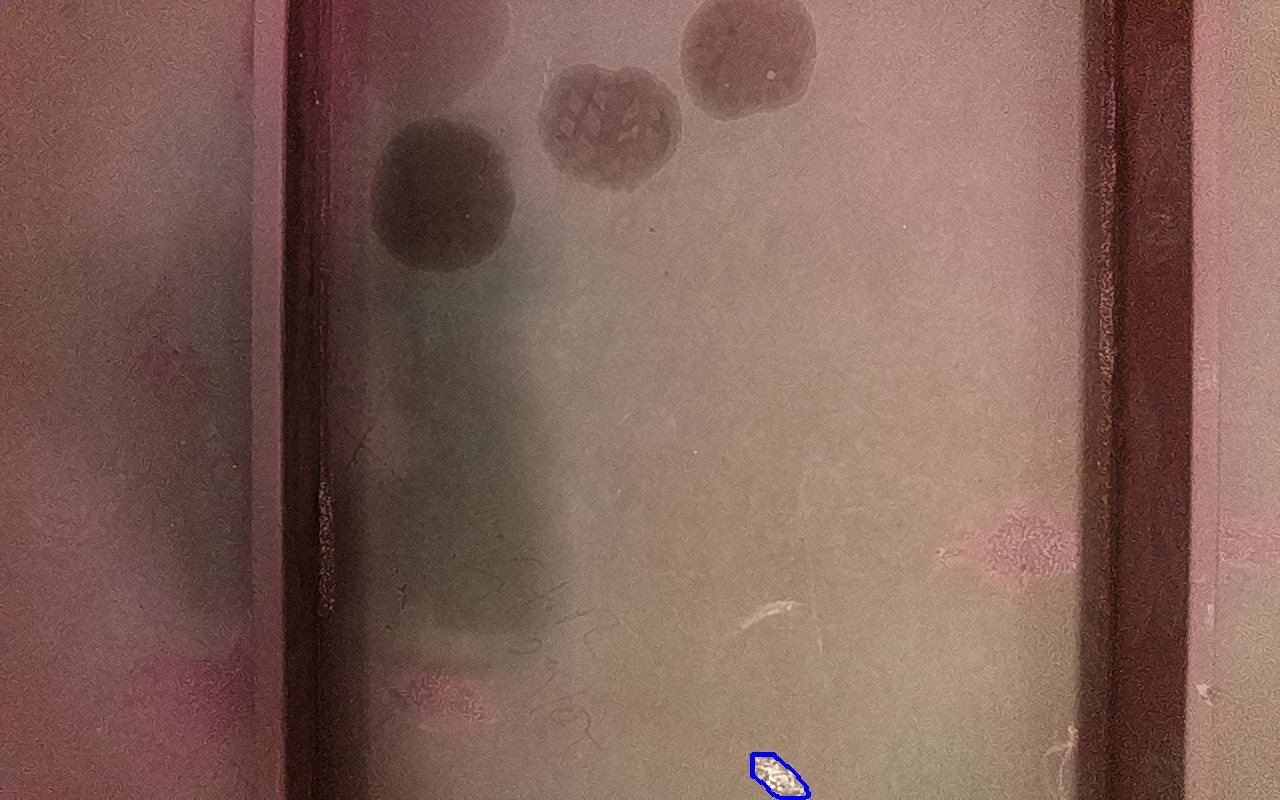

Proviene de:
IV-2
ID: 256389

Confianza: 19.67 %
1052 mm2
(x: 2.37, y: -0.21, z: 0.01)
Marcas de aceite o grasa. Suciedades o todo tipo de contaminantes solubles.
Incluído en discontinuidad final: 266037
IV-2
ID: 256401

Confianza: 10.41 %
1012 mm2
(x: 2.37, y: -0.21, z: 0.01)
Marcas de aceite o grasa. Suciedades o todo tipo de contaminantes solubles.
Incluído en discontinuidad final: 266037
IV-1A
ID: 256410
Confianza: 11.72 %
1033 mm2
(x: 2.37, y: -0.23, z: 0.01)
Rayaduras, marcas, daños por impacto, abrasión o zonas de metal expuestas con apariencia metálica y libre de productos de óxido o con trazas firmemente adheridas.
Incluído en discontinuidad final: 266037
IV-1A
ID: 256423

Confianza: 10.17 %
1002 mm2
(x: 2.37, y: -0.23, z: 0.01)
Rayaduras, marcas, daños por impacto, abrasión o zonas de metal expuestas con apariencia metálica y libre de productos de óxido o con trazas firmemente adheridas.
Incluído en discontinuidad final: 266037
IV-1A
ID: 256433

Confianza: 9.95 %
1076 mm2
(x: 2.37, y: -0.25, z: 0.0)
Rayaduras, marcas, daños por impacto, abrasión o zonas de metal expuestas con apariencia metálica y libre de productos de óxido o con trazas firmemente adheridas.
Incluído en discontinuidad final: 266037
IV-1A
ID: 256442

Confianza: 9.95 %
1071 mm2
(x: 2.37, y: -0.25, z: 0.0)
Rayaduras, marcas, daños por impacto, abrasión o zonas de metal expuestas con apariencia metálica y libre de productos de óxido o con trazas firmemente adheridas.
Incluído en discontinuidad final: 266037
IV-1A
ID: 256492

Confianza: 5.94 %
1264 mm2
(x: 2.33, y: -0.25, z: 0.01)
Rayaduras, marcas, daños por impacto, abrasión o zonas de metal expuestas con apariencia metálica y libre de productos de óxido o con trazas firmemente adheridas.
Incluído en discontinuidad final: 266037
IV-1B
ID: 256493

Confianza: 4.99 %
1323 mm2
(x: 2.33, y: -0.25, z: 0.01)
Rayaduras o zonas de metal expuestas con productos de óxido débilmente adherido.
Incluído en discontinuidad final: 266037
IV-1A
ID: 256496

Confianza: 7.85 %
1279 mm2
(x: 2.33, y: -0.25, z: 0.01)
Rayaduras, marcas, daños por impacto, abrasión o zonas de metal expuestas con apariencia metálica y libre de productos de óxido o con trazas firmemente adheridas.
Incluído en discontinuidad final: 266037
IV-1B
ID: 256497

Confianza: 5.83 %
1323 mm2
(x: 2.33, y: -0.25, z: 0.01)
Rayaduras o zonas de metal expuestas con productos de óxido débilmente adherido.
Incluído en discontinuidad final: 266037
IV-1A
ID: 256501

Confianza: 15.04 %
1322 mm2
(x: 2.33, y: -0.24, z: 0.02)
Rayaduras, marcas, daños por impacto, abrasión o zonas de metal expuestas con apariencia metálica y libre de productos de óxido o con trazas firmemente adheridas.
Incluído en discontinuidad final: 266037
IV-1B
ID: 256504

Confianza: 7.83 %
1333 mm2
(x: 2.33, y: -0.24, z: 0.01)
Rayaduras o zonas de metal expuestas con productos de óxido débilmente adherido.
Incluído en discontinuidad final: 266037
IV-1A
ID: 256510

Confianza: 8.61 %
1287 mm2
(x: 2.33, y: -0.24, z: 0.01)
Rayaduras, marcas, daños por impacto, abrasión o zonas de metal expuestas con apariencia metálica y libre de productos de óxido o con trazas firmemente adheridas.
Incluído en discontinuidad final: 266037
IV-2
ID: 256511

Confianza: 3.19 %
1278 mm2
(x: 2.33, y: -0.24, z: 0.01)
Marcas de aceite o grasa. Suciedades o todo tipo de contaminantes solubles.
Incluído en discontinuidad final: 266037
IV-2
ID: 256515

Confianza: 16.3 %
1268 mm2
(x: 2.33, y: -0.22, z: 0.02)
Marcas de aceite o grasa. Suciedades o todo tipo de contaminantes solubles.
Incluído en discontinuidad final: 266037
IV-1A
ID: 256522

Confianza: 2.28 %
1242 mm2
(x: 2.33, y: -0.22, z: 0.02)
Rayaduras, marcas, daños por impacto, abrasión o zonas de metal expuestas con apariencia metálica y libre de productos de óxido o con trazas firmemente adheridas.
Incluído en discontinuidad final: 266037
Discontinuidad detectada
| Tipo |
IV-2
Marcas de aceite o grasa. Suciedades o todo tipo de contaminantes solubles. |
|---|---|
| Fecha | 26/06/2025 17:30 |
| Tamaño (mm) | 1333 mm2 |
| Tamaño (m) | 0.0013 m2 |
| Confianza | 19.67 % |
| Posición |
X: 2.34 Y: -0.23 Z: 0.01 |
